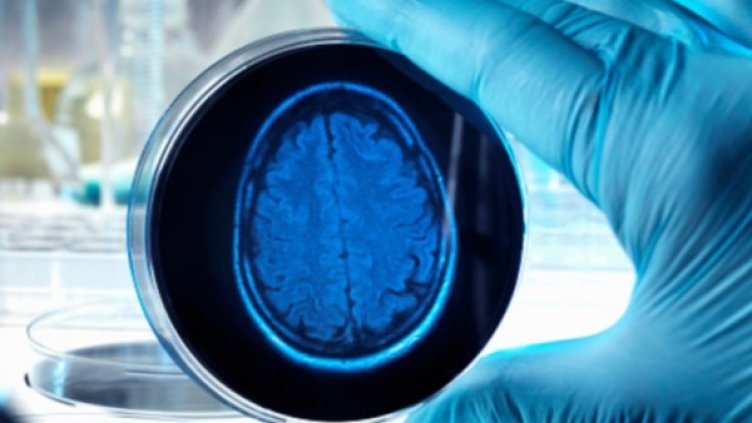
Снимка: Getty Images

Нова конволюционна невронна мрежа използва сканирания на мозъка от позитронна емисионна томография за откриване на биологични признаци на болестта на Алцхаймер години преди появата на симптомите, съобщават изследователи от "Радиологичното дружество на Северна Америка".
Технологията за изкуствен интелект подобрява способността на мозъчното изобразяване да прогнозира болестта на Алцхаймер, според проучване, публикувано в списание "Radiology".
Навременната диагноза на болестта на Алцхаймер е изключително важна, тъй като лечението и интервенциите са по-ефективни в началото на заболяването. Ранната диагноза обаче се оказва предизвикателство. Изследванията свързват процеса на заболяването с промени в метаболизма, но тези промени могат да бъдат трудно разпознати.
Чрез дълбокото учене алгоритъмът, създаден от изследователите успява да се научи именно на метаболитните модели, които съответстват на болестта на Алцхаймер.
Учените са го тествали на независим набор от 40 изследвания на изображения от 40 пациенти, които никога не са изследвали. Алгоритъмът постига 100% чувствителност при откриване на заболяването със средно повече от шест години преди окончателната диагноза.
Алгоритъмът може да бъде полезен инструмент за допълване на работата на радиолозите - особено във връзка с други биохимични и изображения тестове, осигуряващи възможност за ранна терапевтична интервенция.
Когато вече има симптоми на болестта на Алцхаймер, загубата на мозъчен обем е толкова значима, че е твърде късно да за намеса.
"Ако можем да го открием по-рано, това е възможност за следователите потенциално да намерят по-добри начини да забавят или дори да спрат болестния процес", обяснява д-р Сон от Катедрата по радиология и биомедицински изображения в Калифорнийския университет в Сан Франциско, съавтор на изследването.
Бъдещите насоки на изследването включват обучение на алгоритъма за дълбоко учене да търси модели, свързани с натрупването на бета-амилоидни и тау протеини, които са маркери, специфични за болестта на Алцхаймер.
Това се случи Dnes, за важното през деня ни последвайте и в Google News Showcase.

Кадър на деня за 20 юни
Кадър на деня за 20 юни  Как ястребовата политика на централните банки влияе на пазарите на акции?
Как ястребовата политика на централните банки влияе на пазарите на акции?  Преломен момент настъпва във войната в Украйна
Преломен момент настъпва във войната в Украйна  Енергийният министър очаква споразумението с "Боташ" да се предоговори до един-два месеца
Енергийният министър очаква споразумението с "Боташ" да се предоговори до един-два месеца  Империята на ислямската гвардия ще спечели най-много от отмяна на санкциите срещу Иран
Империята на ислямската гвардия ще спечели най-много от отмяна на санкциите срещу Иран  Иран пак затвори Ормузкия проток
Иран пак затвори Ормузкия проток 
 Забрани и традиции за църковния празник на 21 юни
Забрани и традиции за църковния празник на 21 юни  Венеция удря туристите с нова шокова такса до 50 евро
Венеция удря туристите с нова шокова такса до 50 евро  14-годишен футболист почина по време на мач
14-годишен футболист почина по време на мач  Шок за Бразилия: Световното приключи за Рафиня
Шок за Бразилия: Световното приключи за Рафиня  Заповед на Тръмп промени емблематичния басейн до Мемориала на Линкълн (СНИМКИ)
Заповед на Тръмп промени емблематичния басейн до Мемориала на Линкълн (СНИМКИ)  Вулканът Семеру изригна: Миньор е с тежки изгаряния
Вулканът Семеру изригна: Миньор е с тежки изгаряния 
 НА ЖИВО: Тунис – Япония - СЪСТАВИ
НА ЖИВО: Тунис – Япония - СЪСТАВИ  Стана ясна заплатата на легендарен треньор, ако се върне в Атина
Стана ясна заплатата на легендарен треньор, ако се върне в Атина  Спортът по телевизията днес, 21 юни
Спортът по телевизията днес, 21 юни  Мачовете по телевизията днес, 21 юни
Мачовете по телевизията днес, 21 юни  Германия удари Кот д'Ивоар в 94-ата минута и спря прокобата
Германия удари Кот д'Ивоар в 94-ата минута и спря прокобата  ПО МИНУТИ: Германия - Кот д'Ивоар 2:1
ПО МИНУТИ: Германия - Кот д'Ивоар 2:1 
 Нумерологична прогноза за 21 юни
Нумерологична прогноза за 21 юни  Седмична таро прогноза за 22 - 28 юни
Седмична таро прогноза за 22 - 28 юни  Дневен хороскоп за 21 юни, неделя
Дневен хороскоп за 21 юни, неделя  Седмична нумерологична прогноза за 22 - 28 юни
Седмична нумерологична прогноза за 22 - 28 юни  5 любопитни ритуала за 21 юни, когато настъпва астрономическото лято
5 любопитни ритуала за 21 юни, когато настъпва астрономическото лято  3 слънчеви десерта за 21 юни – ден на лятното слънцестоене
3 слънчеви десерта за 21 юни – ден на лятното слънцестоене 
 продава, Двустаен апартамент, 55 m2 Варна, м-т Пчелина, 93500 EUR
продава, Двустаен апартамент, 55 m2 Варна, м-т Пчелина, 93500 EUR  продава, Двустаен апартамент, 55 m2 Варна, м-т Пчелина, 93500 EUR
продава, Двустаен апартамент, 55 m2 Варна, м-т Пчелина, 93500 EUR  продава, Тристаен апартамент, 89 m2 Варна, 149000 EUR
продава, Тристаен апартамент, 89 m2 Варна, 149000 EUR  продава, Едностаен апартамент, 63 m2 Пловдив, Остромила, 89800 EUR
продава, Едностаен апартамент, 63 m2 Пловдив, Остромила, 89800 EUR  продава, Двустаен апартамент, 67 m2 Бургас, Меден Рудник, 122000 EUR
продава, Двустаен апартамент, 67 m2 Бургас, Меден Рудник, 122000 EUR  продава, Тристаен апартамент, 110 m2 София, Овча Купел, 360000 EUR
продава, Тристаен апартамент, 110 m2 София, Овча Купел, 360000 EUR 
 Нидерландия разби Швеция с 5:1 на Мондиала
Нидерландия разби Швеция с 5:1 на Мондиала  И тримата пострадали работници на АПИ са с опасност за живота
И тримата пострадали работници на АПИ са с опасност за живота  Седмичен хороскоп 22 юни - 28 юни 2026
Седмичен хороскоп 22 юни - 28 юни 2026  Зеленски върна отличието "Орден на Белия орел" на Полша
Зеленски върна отличието "Орден на Белия орел" на Полша  Утре настъпва Астрономическото лято
Утре настъпва Астрономическото лято  Цените на горивата у нас вървят надолу
Цените на горивата у нас вървят надолу 
 Човешкият ум може да не е уникален: Учени стигнаха до необичайни заключения
Човешкият ум може да не е уникален: Учени стигнаха до необичайни заключения  След 100 години: Физици обясниха „най-голямата грешка“ на Айнщайн
След 100 години: Физици обясниха „най-голямата грешка“ на Айнщайн  С какво биха се хранили извънземните на Земята?
С какво биха се хранили извънземните на Земята?  В Албания намериха уникално светилище на забравени богове
В Албания намериха уникално светилище на забравени богове  Откриха нов клас древни космически обекти в Млечния път
Откриха нов клас древни космически обекти в Млечния път  НАСА разширява партньорството си с частния сектор за сателитни данни
НАСА разширява партньорството си с частния сектор за сателитни данни 










